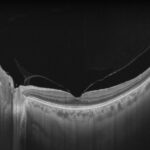
b37b2af1-98ad-4248-9e79-084a8386a500

Talepleriniz
İletişim bilgilerinizi vererek sizlere ulaşabilir ve Yalkaid hakkında daha detaylı bilgi verebiliriz.
Talepleriniz
İletişim bilgilerinizi vererek sizlere ulaşabilir ve Yalkaid hakkında daha detaylı bilgi verebiliriz.